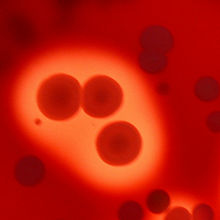
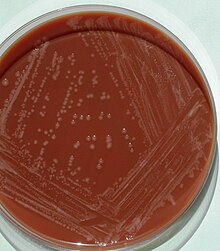

Blutagar

Blutagar dient in der Mikrobiologie
- als Nährboden für Mikroorganismen, die Bestandteile des Blutes von Säugetieren für das Wachstum benötigen,
- zur Untersuchung der Einwirkung von Mikroorganismen auf rote Blutkörperchen (Erythrocyten), beispielsweise Auflösung von Erythrocyten.
Der Nährboden besteht zu 5 bis 10 % aus defibriniertem Blut (in der Regel Schaf- oder Pferdeblut, manchmal auch Kaninchenblut, selten Menschenblut; Schweineblut nur für Spezialfälle) und ermöglicht den Nachweis bestimmter Erregerklassen und die Beurteilung hämolysierender Eigenschaften der kultivierten Bakterien (z. B. Streptokokken). Der Blutagar kann auch mit einem Zusatz von Antibiotika verwendet werden.
Hämolyse-Arten
- α-Hämolyse (Alpha-Hämolyse): Die Bakterien produzieren keine Hämolysine, sie rufen auf Blutagar eine grünliche Zone hervor, die nicht auf eine echte Hämolyse, sondern auf eine Entfärbung und einen Kaliumverlust der roten Blutkörperchen zurückzuführen ist.[1] Die Reduktion des roten Blutfarbstoffes Hämoglobins zu Biliverdin verursacht die grüne Färbung, die Alpha-Hämolyse wird daher auch als Vergrünung bezeichnet. Es finden sich noch intakte Erythrozyten.
- β-Hämolyse (Beta-Hämolyse): Die Bakterien produzieren Streptolysin O oder S und sind von einer klaren Hämolysezone umgeben. Das Hämoglobin wird vollständig abgebaut, es handelt sich hierbei um eine echte Hämolyse.[1] In diesem Bereich sind alle Erythrozyten vollständig hämolysiert.
- γ-Hämolyse (Gamma-Hämolyse): Diese Bakterien zeigen keinerlei Hämolyseverhalten.
Verwendete Arten von Blutagar
Basis für Blutagar
Für die schnelle Zubereitung von gebrauchsfertigen Petrischalen mit dem Nährmedium Blutagar wird häufig eine fertige Mischung der getrockneten Bestandteile – mit Ausnahme des Blutes – verwendet. Derartige Granulate oder Pulver enthalten beispielsweise (Angaben in g/l):[2][3]
- Herz-Infus 10,0
- Pepton aus Fleisch 10,0
- Natriumchlorid 5,0
- Agar-Agar 15,0
Die Zahlenangaben geben die Massenkonzentration der Bestandteile (in Gramm pro Liter) im mit Wasser angesetzten Nährmedium wieder. Der pH-Wert soll bei 7,3 liegen.[2] Entweder erfolgt anschließend der Zusatz von Blut oder das Nährmedium kann auch ohne diesen Zusatz für die Kultivierung von anspruchsvollen Mikroorganismen verwendet werden,[2] allerdings lässt sich dann keine Hämolyse erkennen.
Herstellung von Blutagar
Nachdem das Basis-Nährmedium (siehe oben) auf eine Temperatur unter 50 °C abgekühlt ist, wird ein bestimmtes Volumen an defibriniertem Blut eingemischt und das Nährmedium in Petrischalen abgefüllt. Die empfohlene Blutmenge liegt meist bei 50–80 ml[3] (bezogen auf einen Liter Blutagar) bzw. soll einen Anteil von 5–10 % im fertigen Medium erreichen.[2] In der Regel wird Schafblut[2][3][4] oder Kaninchenblut[2] verwendet. Der pH-Wert soll nach Blutzugabe bei 6,8 liegen, damit die Erythrozyten erhalten bleiben.[3] Der abgefüllte, erstarrte Blutagar kann – kühl gelagert – bis zu drei Monate verwendet werden.[3]
Statt des Basis-Nährmediums mit Herz-Extrakt kann auch ein Nährmedium auf der Basis von Soja-Trypton verwendet werden.[4] Für die Kultivierung einiger Bakterien wird eine abweichende Herstellung empfohlen. So gelingt die Isolierung von Mycobacterium tuberculosis und anderen Erregern der Tuberkulose aus Sputum mit einem Blutagar, der 3,0 % Humanblut, 0,1 % Glycerin und Penicillin enthält.[5]
Kochblutagar
Der Kochblutagar (wegen seiner Farbe auch fälschlicherweise Schokoladenagar genannt)[6] ist eine Variante des Blutagars, bei dem durch kurzzeitiges Erhitzen des mit Blut vermengten Mediums auf 80 °C[3] eine Lyse der Erythrozyten erreicht wird. Durch die Lyse werden Hämin („Faktor X“) und NAD+ („Faktor V“) in das Nährmedium freigesetzt, wodurch sich der Agar mittelbraun färbt.[6] Die freigesetzten Wachstumsfaktoren können dort von Bakterien verstoffwechselt werden, die selbst nicht hämolysierend sind (z. B. Haemophilus influenzae).[7] Kochblutplatten werden manchmal in einer Atmosphäre mit erhöhter CO2-Konzentration bebrütet, besonders capnophile Keime, also CO2-bevorzugende Bakterien, sowie sämtliche Neisseria vermehren sich so wesentlich besser.
Columbia-Blutagar
1966 wurde über die Entwicklung eines Nährmediums mit einer neuen Blutagar-Zusammensetzung berichtet, die als Columbia-Agar oder Columbia-Blutagar bezeichnet wurde.[8] Häufig wird sie als Columbia-Agar mit 5 % Schafblut (englisch: Columbia agar with 5 % sheep blood) verwendet und bietet den Vorteil, dass die Kolonien der Bakterien auf diesem Blutagar schneller heranwachsen und größer sind im Vergleich zu anderen Blutagar-Nährmedien.[7] Das verbesserte Wachstum der Bakterien wird auf die Verwendung von zwei unterschiedlichen Peptonen und Hefeextrakt als Quelle für B-Vitamine zurückgeführt.[7]
Ein derartiges Nährmedium besteht meistens aus (Angaben in Gramm pro Liter):[7]
- Pankreatisch abgebautes Casein 12,0
- Peptisch abgebautes Tiergewebe 5,0
- Hefeextrakt 3,0
- Rindfleischextrakt 3,0
- Maisstärke 1,0
- Natriumchlorid 5,0
- Agar-Agar 13,5
- defibriniertem Schafblut 5 %

Statt Schafblut kann auch Pferdeblut verwendet werden, das so erhaltene Nährmedium wird z. B. als Columbia-Agar mit 5 % Pferdeblut (englisch: Columbia agar with 5 % horse blood oder einfach nur Columbia horse blood agar) bezeichnet.[9] Columbia-Blutagar wird in den mikrobiologisch-infektiologischen Qualitätsstandards (MiQ) der Deutschen Gesellschaft für Hygiene und Mikrobiologie (DGHM) als Nährmedium zur Erstisolierung bei zahlreichen klinischen Proben empfohlen.[10] Die mit dem Probematerial beimpften Nährmedien werden anschließend bei einer Temperatur von 35 ± 2 °C in einer mit Kohlenstoffdioxid (CO2) angereicherten aeroben Atmosphäre inkubiert.[7]
Zahlreiche Mikroorganismen, die in der medizinischen Mikrobiologie als Krankheitserreger von Interesse sind, wachsen auf diesem Medium, beispielsweise Vertreter der Familie Enterobacteriaceae, Pseudomonas-Arten und weitere aerobe gramnegative Stäbchen. Bei den grampositiven Bakterien ist das Nährmedium u. a. für Streptokokken, Enterokokken, Staphylokokken und Corynebakterien geeignet. Weiterhin lassen sich Vertreter der Hefe-Gattung Candida damit kultivieren.[7]
Kochsalz-Blutagar
Kochsalz-Blutagar ist mit 7,5 % Kochsalz versetzt. Er wird vor allem zur Anzucht von Staphylokokken verwendet, der Salzzusatz unterdrückt die Begleitflora.
Blutagar mit Antibiotika
Für die möglichst selektive Isolierung einiger Bakterien kann ein Blutagar mit Zusatz eines bestimmten Antibiotikums oder mehrerer Antibiotika eingesetzt werden, um die übrige Begleitflora zu hemmen.[11]
CNA-Blutagar
Eine Weiterentwicklung des Columbia-Blutagar stellt der CNA-Blutagar, oder auch kurz CNA-Agar dar.[12] Der Name des CNA-Agars verweist auf die zwei im Nährmedium enthaltenen Antibiotika Colistin (Polymyxin E) und Nalidixinsäure. Sie sind meist in einer Massenkonzentration von jeweils 10 mg/l enthalten, die weitere Zusammensetzung entspricht der des Columbia-Blutagars mit 5 % Schafblut.[12] Die beiden zusätzlich enthaltenen Wirkstoffe unterdrücken das Wachstum der gramnegativen Bakterien, so dass CNA-Agar als Selektivmedium zur Isolierung von grampositiven Bakterien (v. a. Streptokokken und Staphylokokken) aus zahlreichen klinischen und nicht-klinischen Proben verwendet wird.[12]
Hefen wie Candida werden nicht im Wachstum gehemmt und auch gramnegative Bakterien, die gegen die verwendeten Antibiotika resistent sind, können auf dem CNA-Agar wachsen. Es gibt leicht modifizierte Varianten, die neben einer geringeren Konzentration an Nalidixinsäure auch noch ein drittes Antibiotikum – Aztreonam – enthalten, das diese gramnegativen Bakterien hemmen soll.[13]
Blutagar mit anderen Antibiotika
Ein weiteres Beispiel für einen Blutagar mit Zusatz eines Antibiotikums ist der Gentamicin-Blutagar (GBA), der auf dem Columbia-Blutagar basiert (mit 10 % Schafblut) und zusätzlich 5,5 mg/l Gentamicin enthält. Mit diesem Nährmedium gelingt die selektive Kultivierung von Streptococcus pneumoniae und anderen Streptokokken, außerdem von Spezies aus den Gattungen Bacteroides, Clostridium und verschiedener Hefen.[14][11]
Um Aeromonas-Arten selektiv aus menschlichen und tierischen Kotproben zu isolieren, wird der Zusatz von Ampicillin empfohlen. Untersuchungen von verschiedenen Selektivmedien für Aeromonas haben gezeigt, dass ein Columbia-Blutagar (mit 5 % Schafblut) mit einem Zusatz von 30 mg/l Ampicillin die höchste Wiederfindungsrate (98 %) erzielt. Ein derartiges Medium wird auch als ASBA 30 bezeichnet (Ampicillin-Schafblut-Agar mit 30 mg/l Ampicillin).[15]
Die American Public Health Association (die Gesundheitsbehörde in den USA) empfiehlt in ihren Richtlinien zur mikrobiologischen Untersuchung von Lebensmitteln unter anderem den Zusatz folgender Antibiotika: Ampicillin, Cycloheximid, Moxalactam, Novobiocin, Oxytetracyclin und Polymyxin B.[11]
Einzelnachweise
[Bearbeiten | Quelltext bearbeiten]- ↑ Hochspringen nach: a b Michael T. Madigan, John M. Martinko, Jack Parker: Brock Mikrobiologie. Deutsche Übersetzung herausgegeben von Werner Goebel, 1. Auflage. Spektrum Akademischer Verlag GmbH, Heidelberg/Berlin 2000, ISBN 978-3-8274-0566-1, S. 562.
- ↑ Hochspringen nach: a b c
d e fTechnische Informationen Blutagar (Basis). In:
 Carl Roth GmbH & Co. KG. abgerufen am 24. Januar 2026.
Carl Roth GmbH & Co. KG. abgerufen am 24. Januar 2026.
- ↑ Hochspringen nach: a b c
d e f Datenblatt
 Blut-Agar bei Merck KGaA, abgerufen am 24. Januar 2026.
Blut-Agar bei Merck KGaA, abgerufen am 24. Januar 2026.
- ↑ Hochspringen nach: a b
 Bacteriological Analytical Manual, Media 20: Blood Agar. In: Webseite der
Food and Drug Administration (FDA)., abgerufen am 24. Januar 2026.
Bacteriological Analytical Manual, Media 20: Blood Agar. In: Webseite der
Food and Drug Administration (FDA)., abgerufen am 24. Januar 2026.
- ↑ M. S. Tarshis et al.: Further experience with a new blood medium for the cultivation of Mycobacterium tuberculosis. In:
American Journal of Public Health and the Nation's Health. Band 45,
Nr. 9, September 1955, S. 1157–1161,
doi:
 10.2105/ajph.45.9.1157,
10.2105/ajph.45.9.1157,
 PMID 13249005,
PMID 13249005,
 PMC 1623456 (freier Volltext).
PMC 1623456 (freier Volltext).
- ↑ Hochspringen nach: a b Herbert Hof und Rüdiger Dörries: Medizinische Mikrobiologie. 5. Auflage. Thieme, Stuttgart 2014, ISBN 978-3-13-152965-7, S. 428.
- ↑ Hochspringen nach: a b c
d e f
 Columbia Agar with 5% Sheep Blood. In:
Webseite von Becton, Dickinson and Company (BD). Abgerufen am 24. Januar 2026.
Columbia Agar with 5% Sheep Blood. In:
Webseite von Becton, Dickinson and Company (BD). Abgerufen am 24. Januar 2026.
- ↑ P. D. Ellner et al.: A new culture medium for medical bacteriology. In: American Journal of
Clinical Pathology. Band 45, Nr. 4, April 1966,
S. 502–504,
doi:
 10.1093/ajcp/45.4_ts.502,
10.1093/ajcp/45.4_ts.502,
 PMID 5325709.
PMID 5325709.
- ↑ Columbia agar + 5% horse blood. In: Webseite der bioMérieux Deutschland GmbH. Abgerufen am 26. Dezember 2013.
- ↑ Heft 3, 6 und 7. In: Deutsche Gesellschaft für Hygiene und Mikrobiologie [DGHM]. A. Podbielski, M. Herrmann, E. Kniehl, H. Mauch (Hrsg.): MiQ: Qualitätsstandards in der mikrobiologisch-infektiologischen Diagnostik. MiQ Grundwerk Heft 1–25. 1. Auflage. Urban & Fischer Verlag in Elsevier GmbH, München 1997, ISBN 3-437-41569-7.
- ↑ Hochspringen nach: a b c F. P. Downes, K. Ito (Hrsg.): Compendium of Methods for the Microbiological Examination of Foods. 4. Auflage. American Public Health Association, Washington, DC 2001, ISBN 978-0-87553-175-5, S. 47, 210.
- ↑ Hochspringen nach: a b c
 Columbia CNA Agar with 5% Sheep Blood. In: Webseite von Becton, Dickinson and Company (BD).
Abgerufen am 24. Januar 2026.
Columbia CNA Agar with 5% Sheep Blood. In: Webseite von Becton, Dickinson and Company (BD).
Abgerufen am 24. Januar 2026.
- ↑ Columbia CNA Agar with 5% Sheep Blood, Improved II (deutschsprachige Gebrauchsanweisung, Stand: September 2011). (PDF; 48 kB) In: Webseite von Becton, Dickinson and Company (BD). Abgerufen am 26. Dezember 2013.
- ↑ W. A. Black, F. Van Buskirk: Gentamicin blood agar used as a general-purpose selective medium. In: Applied microbiology.
Band 25, Nummer 6, Juni 1973, S. 905–907,
 PMID 4352009.
PMID 4352009.
 PMC 380938 (freier Volltext).
PMC 380938 (freier Volltext).
- ↑ S. Mishra et al.: Comparison of selective media for primary isolation of Aeromonas species from human and animal feces. In:
Journal of Clinical Microbiology. Band 25,
Nr. 11, November 1987, S. 2040–2043,
 PMID 3693536.
PMID 3693536.


© biancahoegel.de
Datum der letzten Änderung: Jena, den: 24.03. 2026